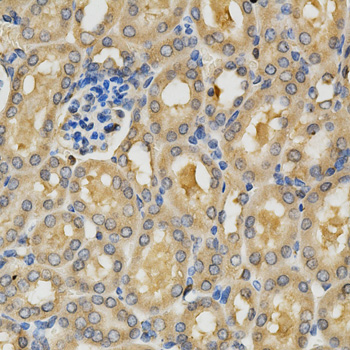
A2548: image 5

For quotations, please use our online quotation form, and you may also contact us by
sales@neoscientific.com
+1-888.733.6849
+1-617.299.7367 (Int’l)
+1-888.733.6849
+1-617.299.7367 (Int’l)
| Reactivity | Human Mouse Rat |
| Tested applications | WB IHC IF |
| Recommended Dilution | WB 1:500 - 1:2000 IHC 1:50 - 1:200 IF 1:50 - 1:200 |
| Calculated MW | 68kDa |
| Observed MW | Refer to Figures |
| Immunogen | Recombinant protein of human PLK1 |
| Storage Buffer | Store at -20℃. Avoid freeze / thaw cycles. Buffer: PBS with 0.02% sodium azide, 50% glycerol, pH7.3. |
| Concentration | d |
| Synonym | PLK; STPK13; |

Western blot analysis of extracts of various cell lines, using PLK1 antibody.

Immunohistochemistry of paraffin-embedded rat testis using PLK1 antibody at dilution of 1:200 (x400 lens)

Immunohistochemistry of paraffin-embedded human stomach using PLK1 antibody at dilution of 1:200 (x400 lens)

Immunohistochemistry of paraffin-embedded human esophageal cancer using PLK1 antibody at dilution of 1:200 (x400 lens)
Immunohistochemistry of paraffin-embedded mouse kidney using PLK1 antibody at dilution of 1:200 (x400 lens)

Immunofluorescence analysis of U2OS cell using PLK1 antibody. Blue: DAPI for nuclear staining.
At least four distinct polo-like kinases exist in mammalian cells: PLK1, PLK2, PLK3, and PLK4/SAK (1). PLK1 apparently plays many roles during mitosis, particularly in regulating mitotic entry and exit. The mitosis promoting factor (MPF), cdc2/cyclin B1, is activated by dephosphorylation of cdc2 (Thr14/Tyr15) by cdc25C. PLK1 phosphorylates cdc25C at Ser198 and cyclin B1 at Ser133 causing translocation of these proteins from the cytoplasm to the nucleus (2-5). PLK1 phosphorylation of Myt1 at Ser426 and Thr495 has been proposed to inactivate Myt1, one of the kinases known to phosphorylate cdc2 at Thr14/Tyr15 (6). Polo-like kinases also phosphorylate the cohesin subunit SCC1, causing cohesin displacement from chromosome arms that allow for proper cohesin localization to centromeres (7). Mitotic exit requires activation of the anaphase promoting complex (APC) (8), a ubiquitin ligase responsible for removal of cohesin at centromeres, and degradation of securin, cyclin A, cyclin B1, Aurora A, and cdc20 (9). PLK1 phosphorylation of the APC subunits Apc1, cdc16, and cdc27 has been demonstrated in vitro and has been proposed as a mechanism by which mitotic exit is regulated (10,11).Substitution of Thr210 with Asp has been reported to elevate PLK1 kinase activity and delay/arrest cells in mitosis, while a Ser137Asp substitution leads to S-phase arrest (12). In addition, while DNA damage has been found to inhibit PLK1 kinase activity, the Thr210Asp mutant is resistant to this inhibition (13). PLK1 has been reported to be phosphorylated in vivo at Ser137 and Thr210 in mitosis; DNA damage prevents phosphorylation at these sites (14).
N/A